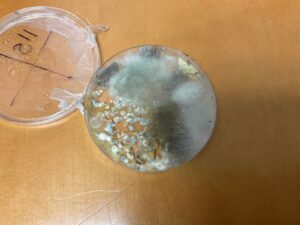
mold growth

Training the Next Generation of Foundation & Waterproofing Industry Experts
To keep our standards high and our craftsmanship unmatched, we created AMC911 University, our in-house training and certification program designed to develop skilled, tech-forward, safety-driven professionals.
Topics Covered in AMC911 University
Through AMC911 University, every team member receives hands-on training in the most advanced tools and systems used in the field today, including:
Drone Technology for Inspections
We train our technicians to operate drones for:
- Roofline and exterior foundation imaging
- Identifying water intrusion pathways
- Hard-to-reach area inspections
- Collecting precise visual data without disruption to the home
Drones allow us to see the full picture safely, efficiently, and with more detail.
Torque Monitoring Systems for Helical Pile Installation
Reliable foundation repair starts with accurate measurements. Our crews are trained to use real-time torque monitoring machines to ensure:
- Proper load-bearing capacity
- Verified installation depths
- Compliance with engineering specifications
- Long-term structural stability
This technology gives homeowners peace of mind and ensures every pile is installed with scientific precision.
Mold Testing & Environmental Diagnostics
Moisture and air quality issues require expertise. At AMC911 University, our technicians learn:
- How to test and identify mold types
- Best practices for safe remediation
- Preventative strategies to stop return growth
We focus on both your home’s structural health and your indoor air quality.
Next Generation Tools & Field Equipment
Students at AMC911 University also receive training on:
- Crawl space encapsulation systems
- Smart monitoring sensors
- Structural lifting and stabilization equipment
- Waterproofing technology and materials
This ensures our entire team is confident, competent, and consistent, no matter which AMC911 crew arrives at your home.

Leading the Industry Forward
AMC911 Foundation & Crawl Space Repair is proud to be more than a service provider… We’re a leader in research, education, and innovation within the foundation and crawl space industry.
Through AMC911 University and our ongoing Research & Development initiatives, we ensure that:
- Every project is performed with advanced technology
- Every technician is trained to the highest standard
- Every homeowner receives world-class service backed by real science


